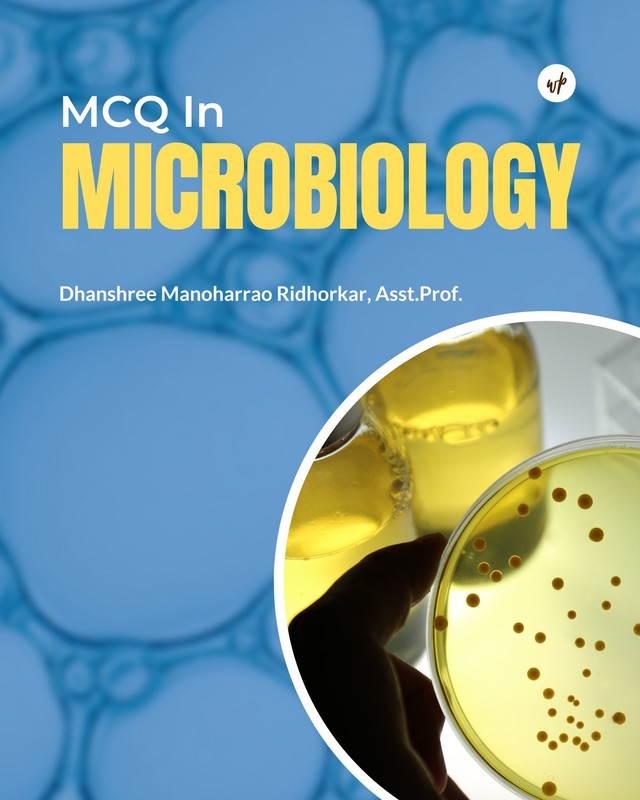

Description
The book is primarily for those students appearing for PG competitive examinations, medical and paramedical entrance examination and also for UG students. The main object of this book is to help the students to review their knowledge of Microbiology acquired through standard book.